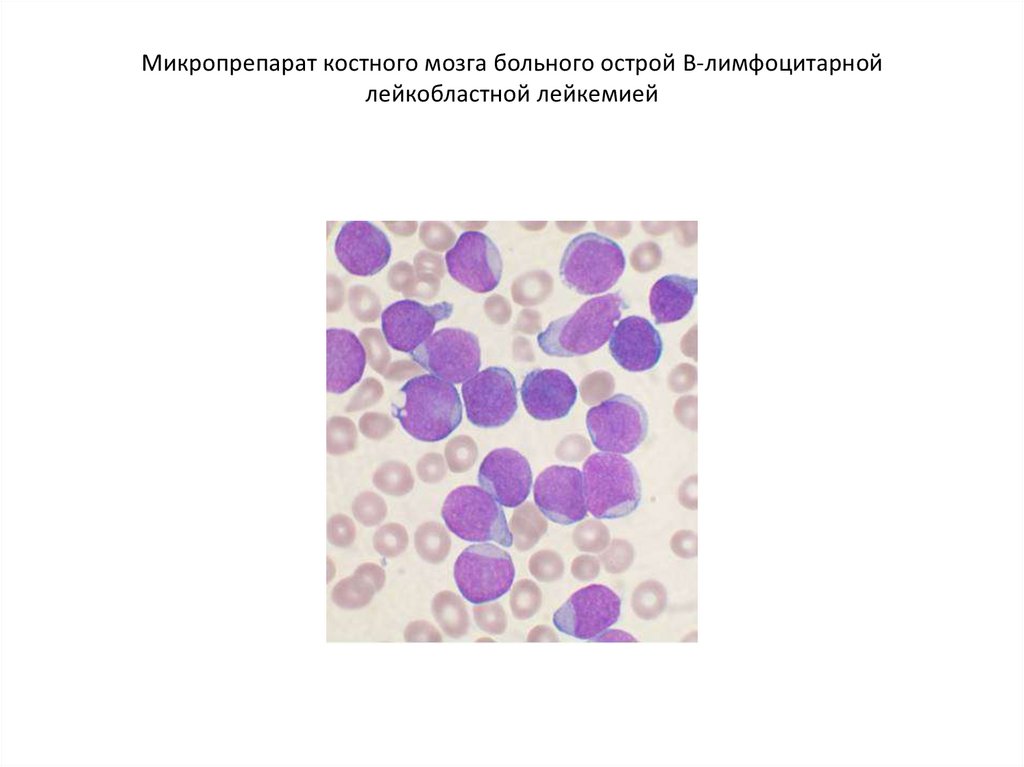
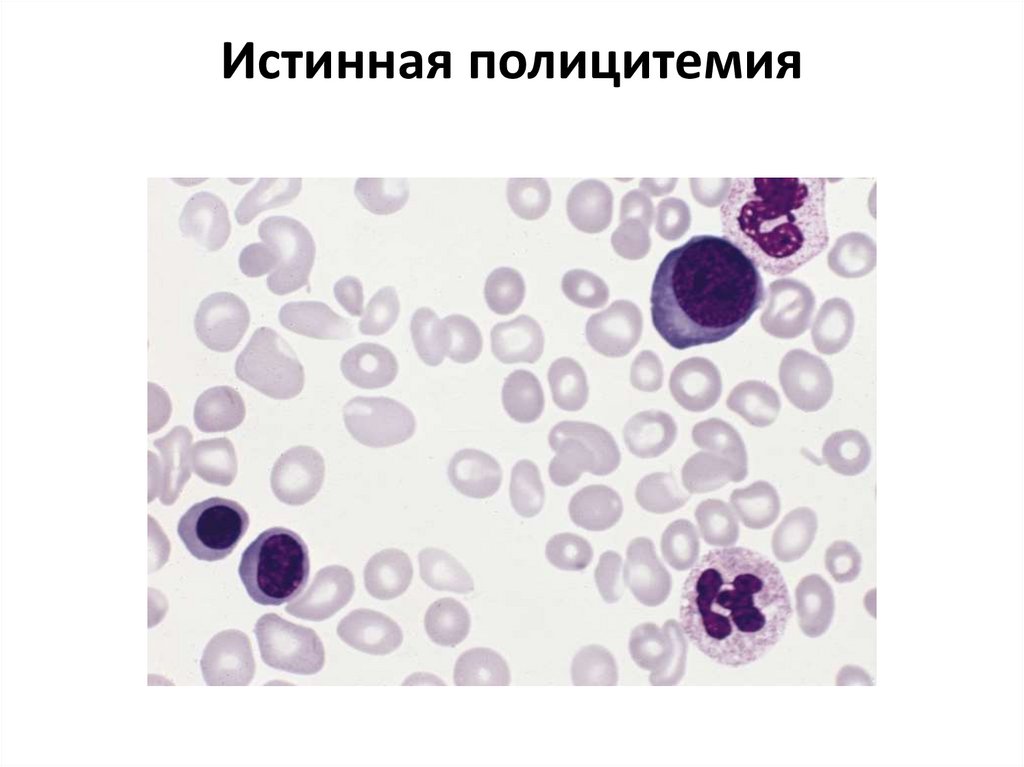
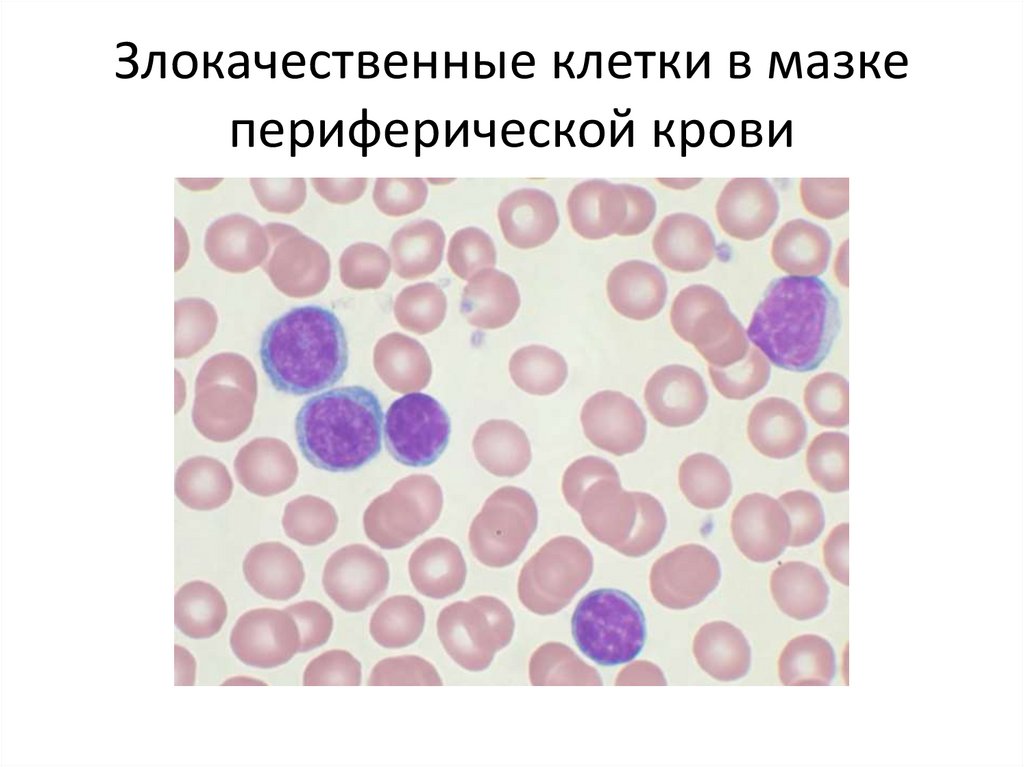

Похожие презентации:
Лейкоз
1.
ЛейкозПодготовил Выползов М., БМаг-103
2.
Лейко́з (греч. λευκός — белый) (лейкеми́я (греч. λευκός —белый и греч. αἷμα — кровь), алейкеми́я, белокровие,
рак крови) — клональное злокачественное
(неопластическое) заболевание кроветворной системы.
К лейкозам относится обширная группа заболеваний,
различных по своей этиологии. При лейкозах
злокачественный клон может происходить как из
незрелых гемопоэтических клеток костного мозга, так и
из созревающих и зрелых клеток крови.
Лейкоз выражается системной диффузной гиперплазией
всего клеточного аппарата, продуцирующего
лейкоциты, независимо от того, сопровождаются ли они
белокровием или протекают без него
3.
Микропрепарат костного мозга больного острой В-лимфоцитарнойлейкобластной лейкемией
4.
5.
Истинная полицитемия6.
Злокачественные клетки в мазкепериферической крови
7.
Миеломная болезнь8.
Лангергансоклеточный гистиоцитозв костной ткани, 10-кратное
увеличение, окрашивание H&E

Медицина
Медицина








